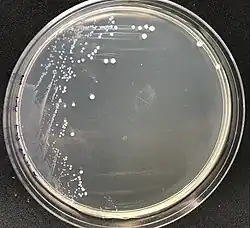

Porphyromonadaceae
| Porphyromonadaceae | |
|---|---|
| |
| Colonies of Porphyromonas gulae growing on a TSA plate | |
| Scientific classification | |
| Domain: | Bacteria |
| Kingdom: | Pseudomonadati |
| Phylum: | Bacteroidota |
| Class: | Bacteroidia |
| Order: | Bacteroidales |
| Family: | Krieg 2012[1] |
| Genera[2] | |
| |
Porphyromonadaceae is a family of Gram-negative bacteria described by Noel R. Krieg in 2015. It contains nine genera, five of which are validly published by the International Code of Nomenclature of Prokaryotes.[2] Bacteria with 16S ribosomal RNA highly similar to the Porphyromonas genus, as compared to the larger taxonomic order Bacteroidales, are classified in this family.[1]
Bacteria of the Porphyromonadaceae family have coccobacilli shapes, and are obligately anaerobic, non-spore forming, and non-motile. Many of its species are members of animal gastrointestinal and oral microbiomes, such as Porphyromonas gingivalis, which causes periodontal disease.[3]
References
Wikispecies has information related to Porphyromonadaceae.
- ^ a b Krieg, Noel R. (14 September 2015). "Porphyromonadaceae fam. nov". Bergey's Manual of Systematics of Archaea and Bacteria. doi:10.1002/9781118960608.fbm00060.
- ^ a b Parte, Aidan C.; Carbasse, Joaquim Sardà; Meier-Kolthoff, Jan P.; Reimer, Lorenz C.; Göker, Markus (23 July 2020). "Family Porphyromonadaceae". List of Prokaryotic names with Standing in Nomenclature. Retrieved 8 April 2023.
- ^ Sakamoto, Mitsuo (2014). "The Family Porphyromonadaceae". In Rosenberg, Eugene; DeLong, Edward F.; Lory, Stephen; Stackebrandt, Erko; Thompson, Fabiano (eds.). The Prokaryotes (4th ed.). Springer Berlin. pp. 811–824. doi:10.1007/978-3-642-38954-2_132. ISBN 978-3-642-38953-5.